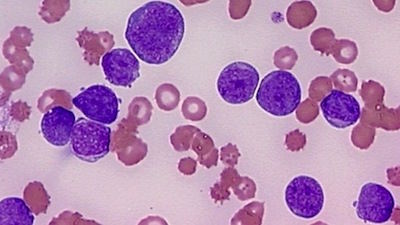

Accédez à tous les articles de cette Newsletter
Effets des faibles doses sur la santé
Les rayonnements ionisants à faible dose seraient responsables de certaines leucémies chez les travailleurs en environnement nucléaire.
Les rayonnements ionisants à faible dose seraient responsables de certaines leucémies chez les travailleurs en environnement nucléaire.
Enceinte au travail
 La femme enceinte, tout au long et après sa grossesse, bénéficie d’un statut très protecteur en matière de santé et de sécurité au travail.
La femme enceinte, tout au long et après sa grossesse, bénéficie d’un statut très protecteur en matière de santé et de sécurité au travail.
Médecine du travail: les obligations
 L’employeur doit proposer à ses salariés plusieurs types de visites obligatoires auprès du médecin du travail.
L’employeur doit proposer à ses salariés plusieurs types de visites obligatoires auprès du médecin du travail.
Défaut dans l’organisation des visites médicales
 L’employeur doit faire en sorte que les visites médicales obligatoires de ses travailleurs soient effectuées … mais il y a des exceptions.
L’employeur doit faire en sorte que les visites médicales obligatoires de ses travailleurs soient effectuées … mais il y a des exceptions.
Contrôle de l’inspection du travail
 L’employeur doit être en mesure de fournir à l’inspecteur tous les documents qu’il demande (livres, registres et autres documents).
L’employeur doit être en mesure de fournir à l’inspecteur tous les documents qu’il demande (livres, registres et autres documents).
Salariés à temps partiel : les congés payés
 Les jours de CP d’un salarié à temps partiel sont décomptés de la même façon qu’un salarié à temps plein.
Les jours de CP d’un salarié à temps partiel sont décomptés de la même façon qu’un salarié à temps plein.
Nous espérons que cette Newsletter cd2-conseils vous a plu et nous attendons vos remarques et suggestions pour l’améliorer.
Bien cordialement,
L’Equipe cd2-conseils
